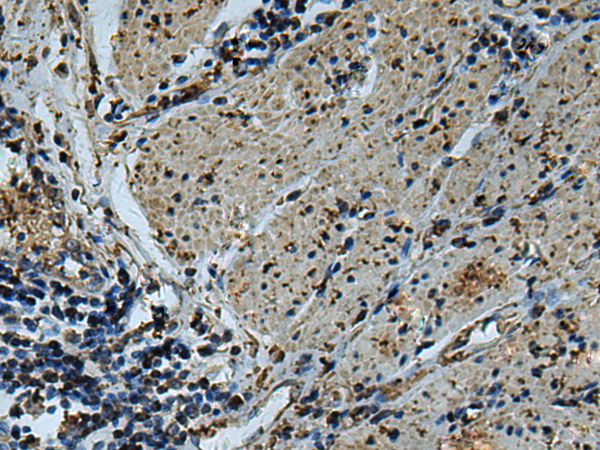
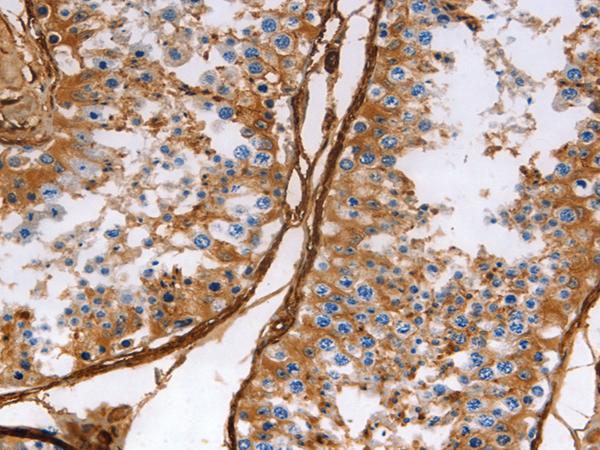
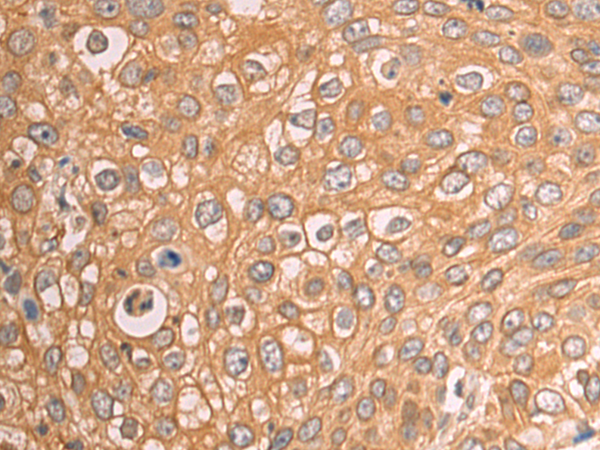

-
分类: 科研抗体货号: P07161别名: APPS, CPSB应用: IHC反应种属: Human, Mouse, Rat
-
分类: 科研抗体货号: P07140别名: CANP; muCL; CANP1; SPG76; CANPL1; muCANP应用: WB,IHC反应种属: Human, Mouse, Rat
-
分类: 科研抗体货号: P07159别名: ACRP; CLLP; alpha-CATU应用: WB反应种属: Human, Mouse
-
分类: 科研抗体货号: P07139别名: CDM, HCAD, LCAD, H-CAD, L-CAD, NAG22应用: WB,IHC反应种属: Human, Rat
-
分类: 科研抗体货号: P07158别名: CAIV; Car4; RP17应用: WB,IHC反应种属: Human, Mouse
-
分类: 科研抗体货号: P07138别名: PC3; APRO1; TIS21应用: WB,IHC反应种属: Human, Mouse, Rat
-
分类: 科研抗体货号: P07157别名: CARPX; CA-RPX; HUCEP-15应用: IHC反应种属: Human, Mouse
-
分类: 科研抗体货号: P07137别名: ANA; TOB5; TOFA; APRO4; TOB55; ANA/BTG3应用: WB,IHC反应种属: Human, Mouse
-
分类: 科研抗体货号: P07156别名: CAXiV应用: WB反应种属: Human, Mouse
-
分类: 科研抗体货号: P07136别名: PC3B应用: IHC反应种属: Human

鄂公网安备42018502007531号
鄂公网安备42018502007531号

